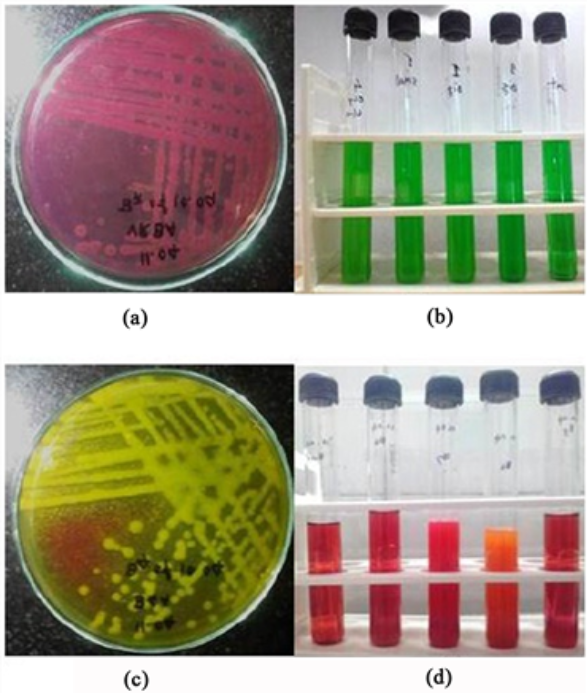

Laboratory of Pharmaceutical Biotechnology
and Bioinformatics
যশোর বিজ্ঞান ও প্রযুক্তি বিশ্ববিদ্যালয়

Laboratory of Pharmaceutical Biotechnology
and Bioinformatics
যশোর বিজ্ঞান ও প্রযুক্তি বিশ্ববিদ্যালয়

Professor
Email: mn.hasan@gmail.com
Department: Department of Genetic Engineering and Biotechnology
Faculty: Faculty of Biological Science and Technology
University: Jashore University Of Science And Technology
Office Address: Jashore-7408, Bangladesh.
Post: Head, Laboratory of Pharmaceutical Biotechnology & Bioinformatics.
Phone: +8801911034367
Skype: azmal98
Google Scholar: Visit Profile
Research Gate: Visit Profile
Prof. Dr. Md. Nazmul Hasan is a Professor in the Department of Genetic Engineering and Biotechnology at Jashore University of Science and Technology (JUST), where he has been since 2010. From 2004 to 2010, he has served as a teacher and researcher in the Dept. of Biotechnology and Genetic Engineering in the University of Development Alternative (UODA), Dhaka Bangladesh. He has obtained his BSc and MS degrees in Biotechnology and Genetic Engineering in 2002 and 2012 respectively from the Khulna University, Bangladesh. He received his Ph.D. in Agriculture from Kyushu University, Japan in 2016. He has also completed a Post-graduation course in Sustainable International Agriculture at the George August University of Gottingen from Germany. His research interests span both in Pharmaceutical biotechnology, including traditional medicine, searching of new lead compounds in the field of drug design and discovery, Searching of anti-cancer agents and bioinformatics. He has already published almost 74 articles including conference proceedings in the National and International conferences. For details about his research field:
No Education available.
No Projects available.
No research available.
No image available
Published: 2024
DOI LinkNo image available
Published: 2024
DOI LinkNo image available
Published: 2024
DOI Link
Published: 2024
DOI LinkNo image available
Published: 2023
DOI Link
Published: 2025
DOI Link
Published: 2024
DOI Link
Published: 2024
DOI Link
Published: 2024
DOI Link
Published: 2024
DOI Link
Published: 2024
DOI Link
Published: 2024
DOI Link
Published: 2024
DOI Link
Published: 2023
DOI Link
Published: 2023
DOI Link
Published: 2023
DOI Link
Published: 2023
DOI Link
Published: 2023
DOI Link
Published: 2023
DOI Link
Published: 2023
DOI Link
Published: 2023
DOI Link
Published: 2023
DOI Link
Published: 2022
DOI Link
Published: 2022
DOI Link
Published: 2022
DOI Link
Published: 2022
DOI Link
Published: 2022
DOI Link
Published: 2022
DOI Link
Published: 2022
DOI Link
Published: 2021
DOI Link
Published: 2021
DOI Link
Published: 2021
DOI Link
Published: 2021
DOI Link
Published: 2021
DOI Link
Published: 2021
DOI Link
Published: 2021
DOI Link
Published: 2020
DOI Link
Published: 2020
DOI Link
Published: 2020
DOI Link
Published: 2020
DOI Link
Published: 2020
DOI Link

Published: 2020
DOI Link
Published: 2019
DOI Link
Published: 2019
DOI Link
Published: 2019
DOI Link

Published: 2018
DOI Link
Published: 2018
DOI Link
Published: 2016
DOI Link
Published: 2016
DOI Link
Published: 2015
DOI Link
Published: 2014
DOI Link
Published: 2015
DOI Link
Published: 2014
DOI LinkNo research interests available.